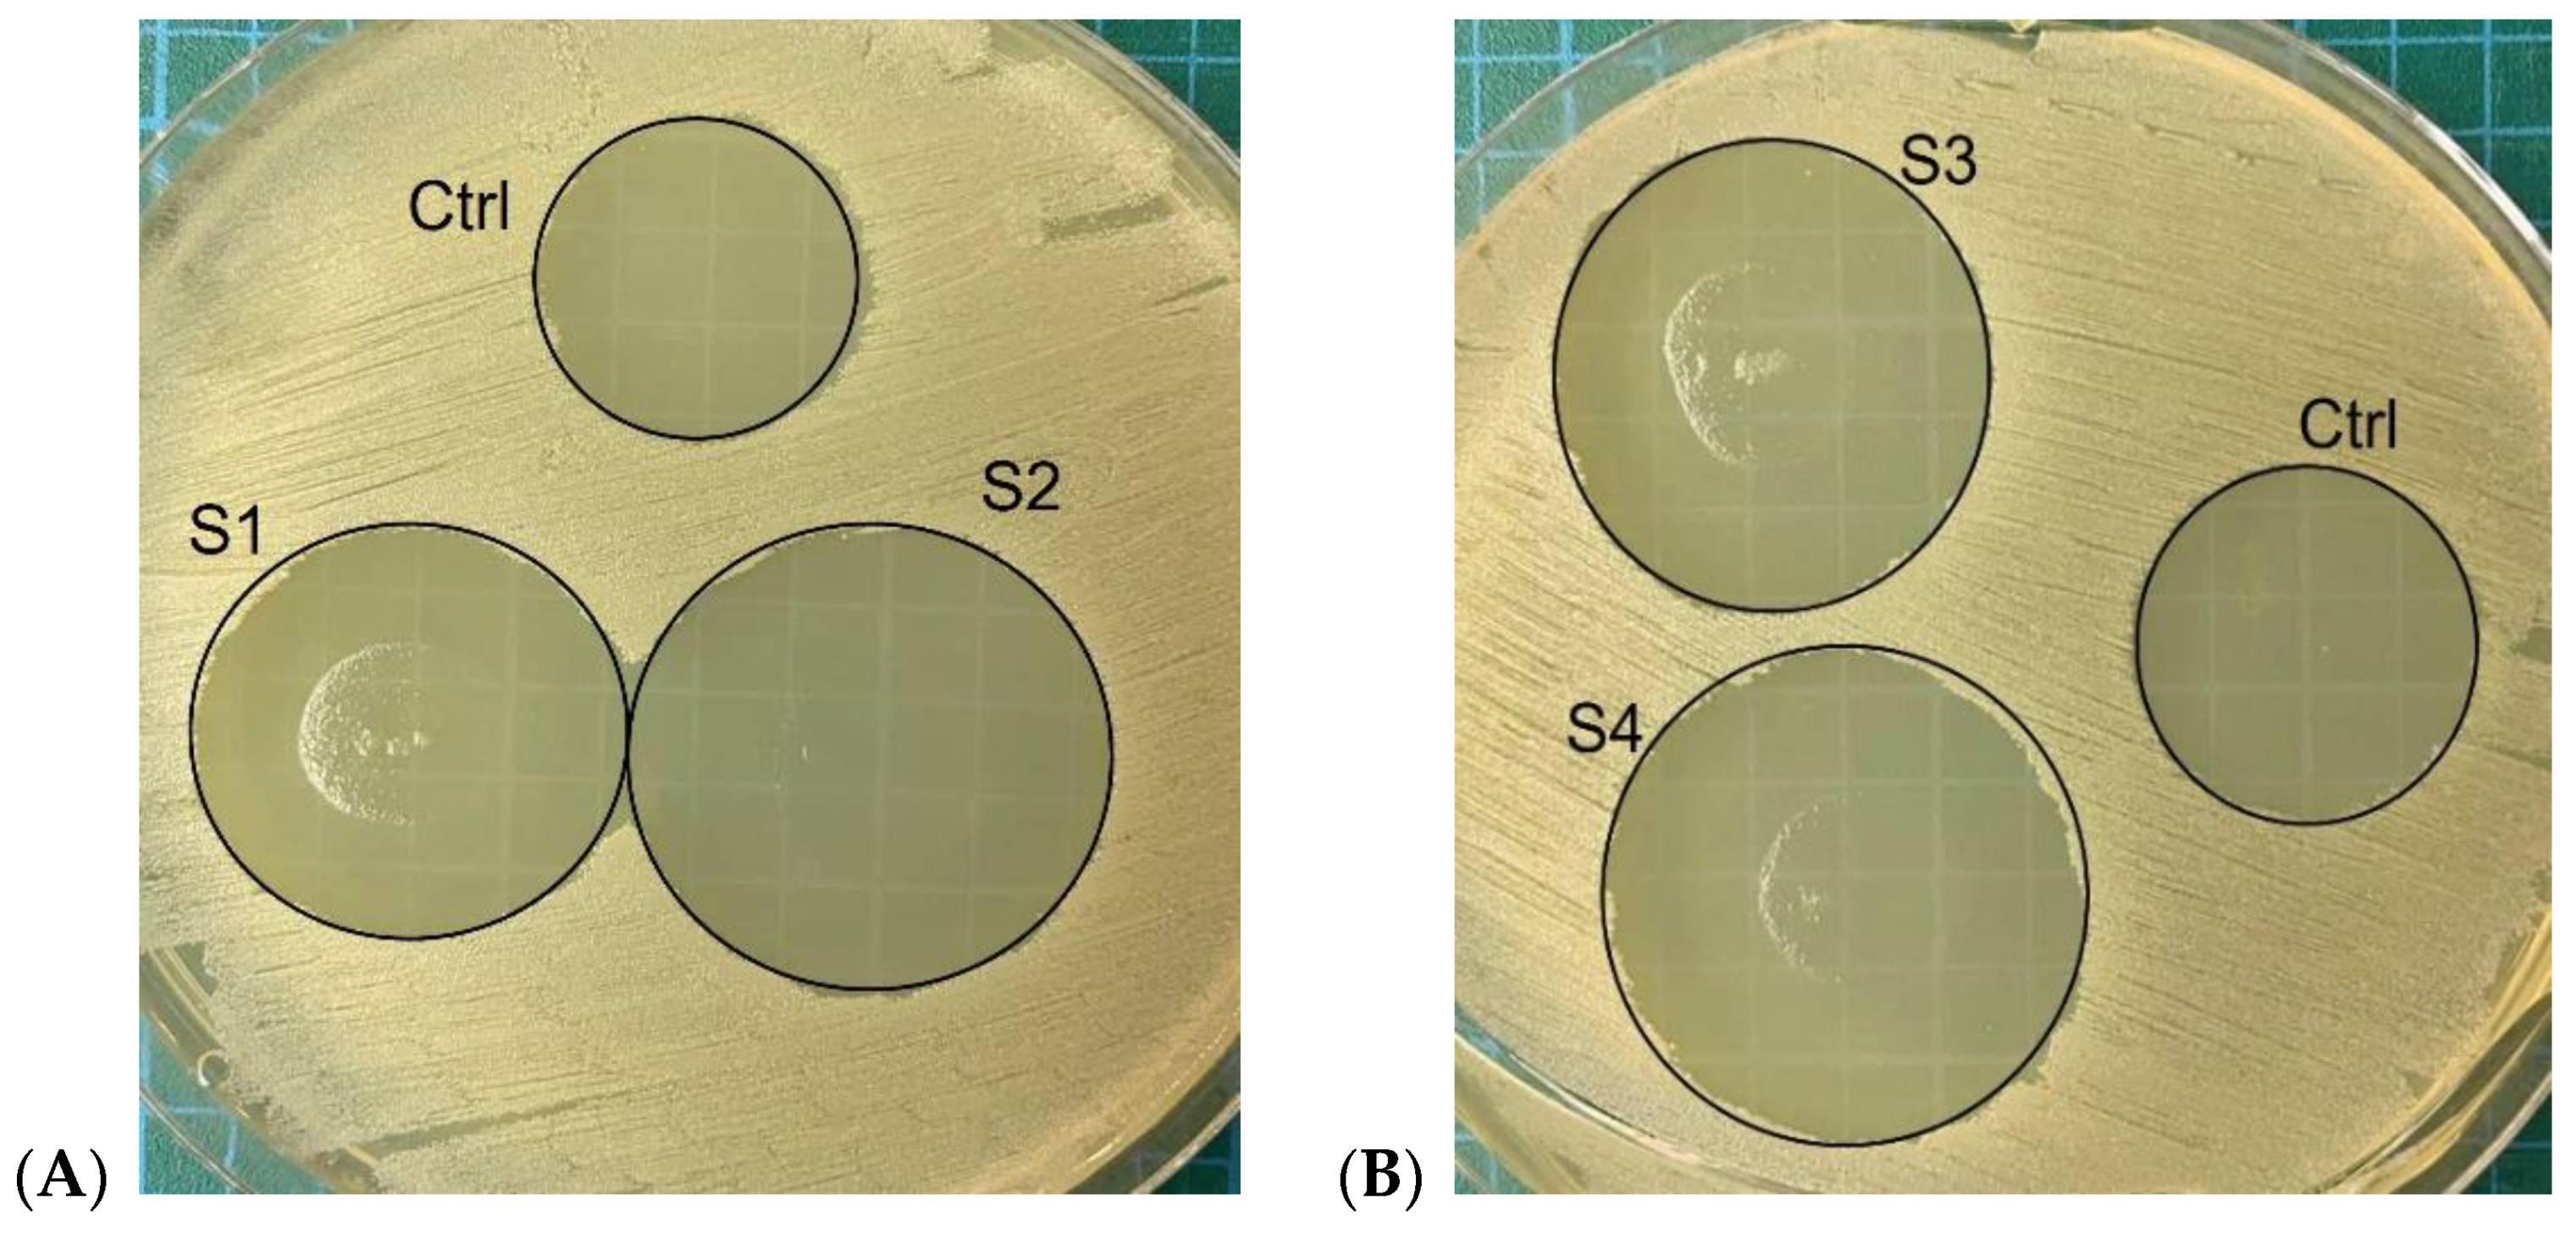
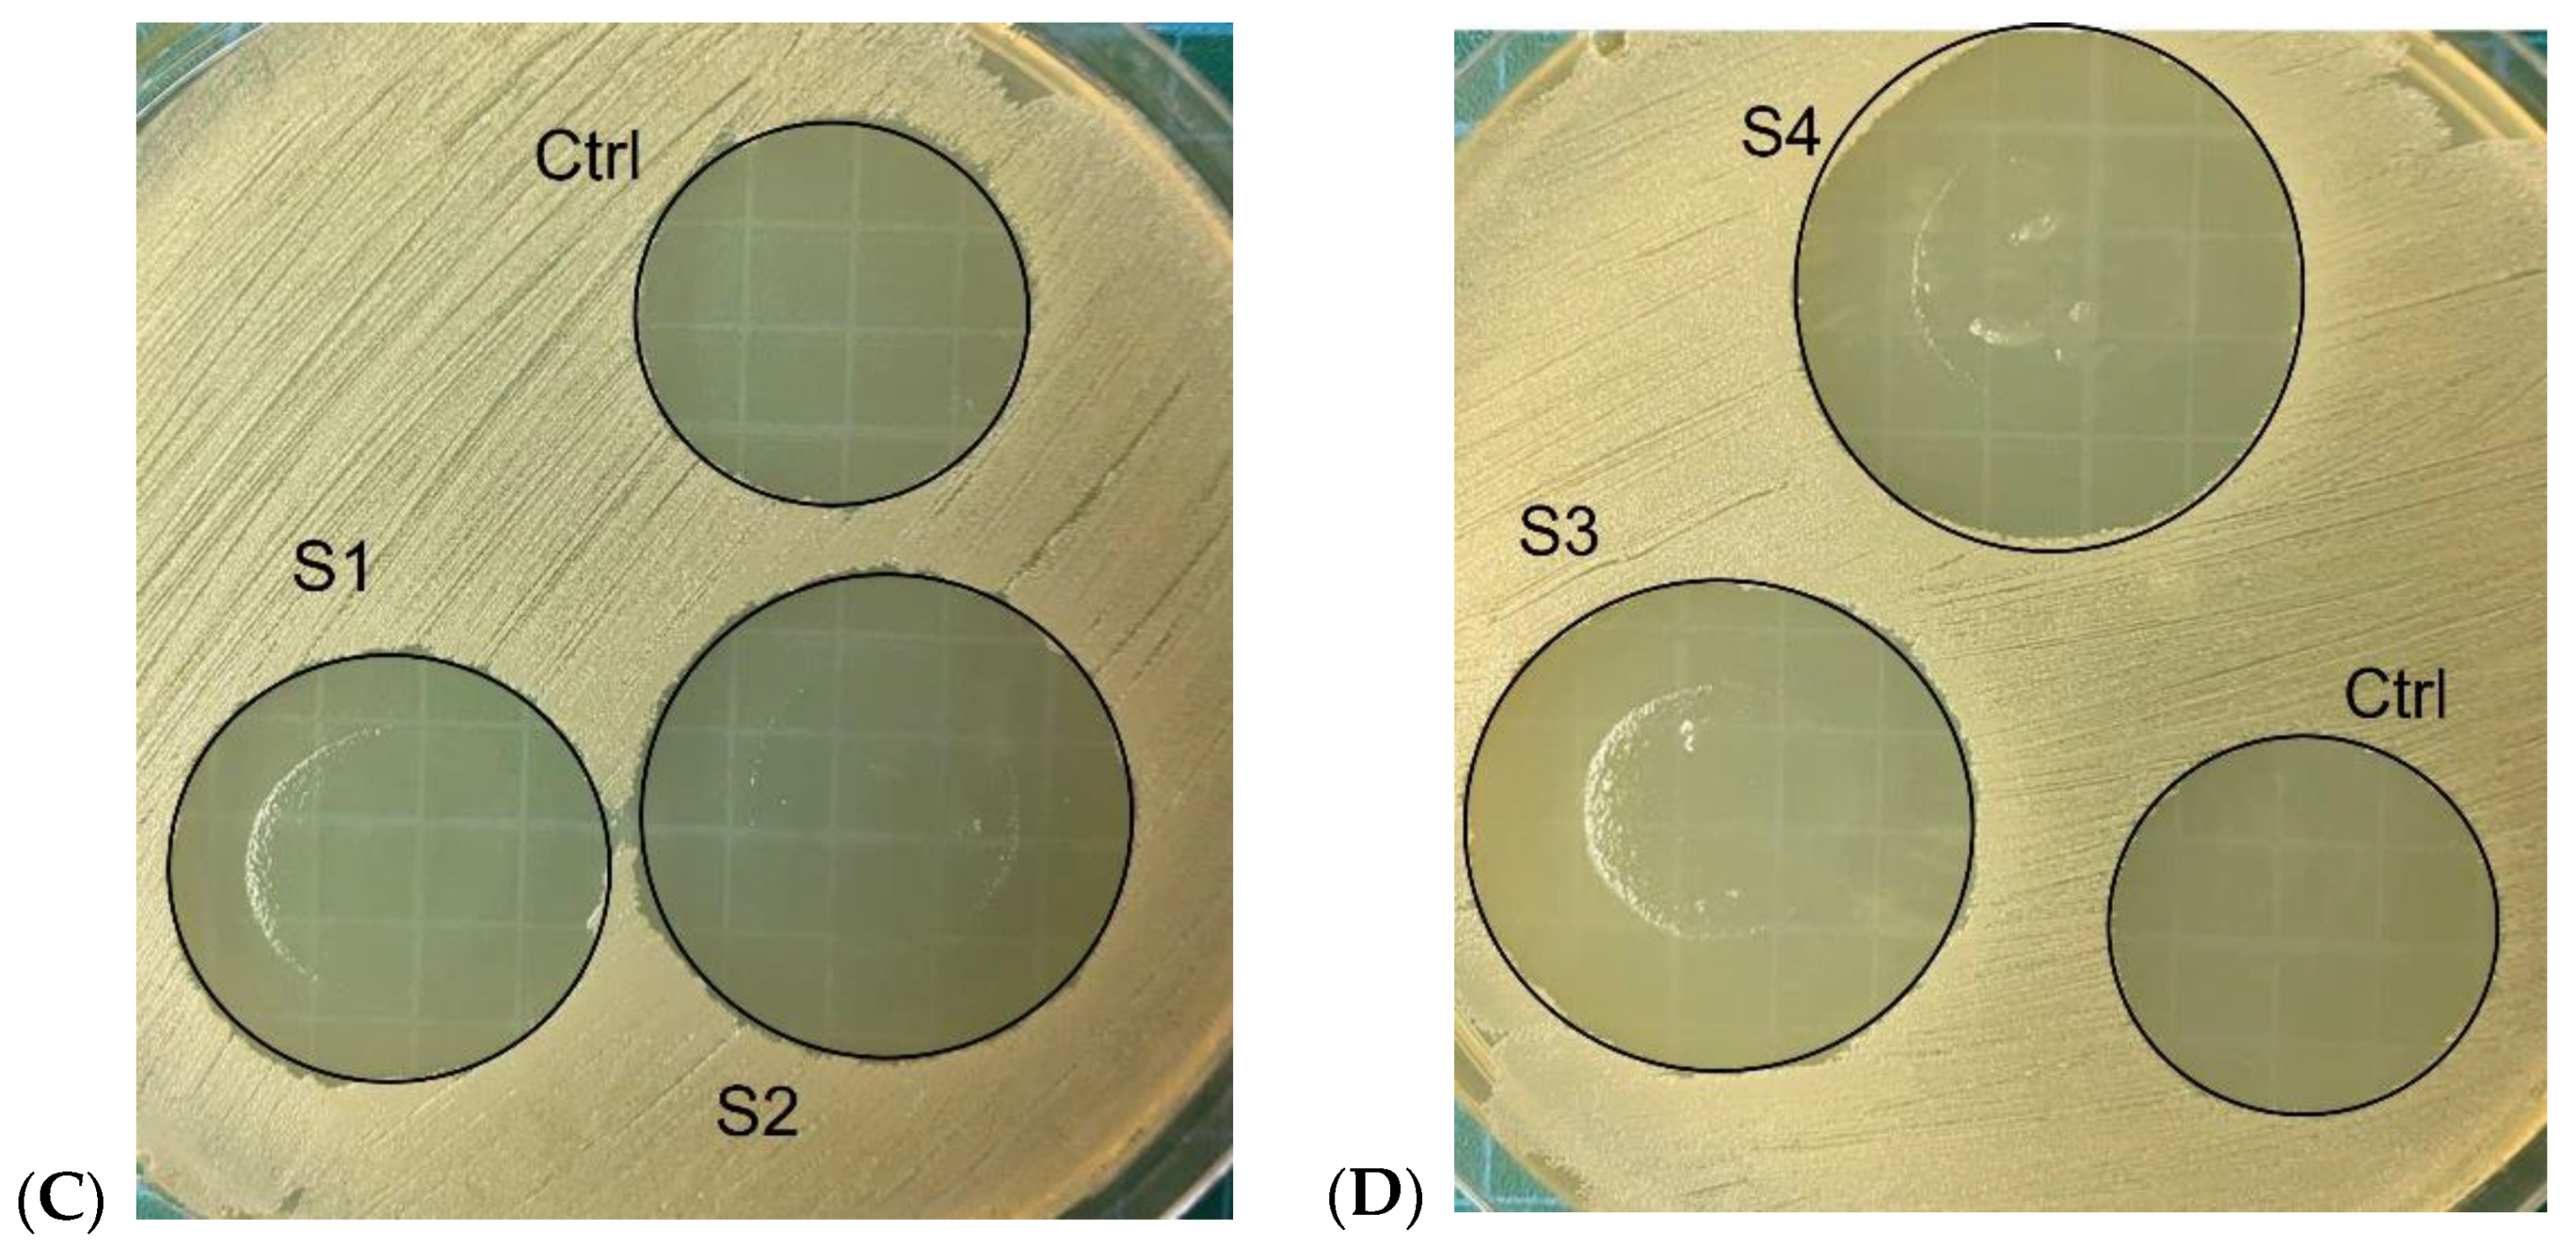

Preparing and Characterizing Novel Biodegradable Starch/PVA-Based Films with Nano-Sized Zinc-Oxide Particles for Wound-Dressing Applications
Abstract
:1. Introduction
2. Materials and Methods
2.1. Blends Preparation Procedure
2.2. Water Vapor Transmission Rate (WVTR)
2.3. UV–Vis and IR Spectroscopy
2.4. Swelling Index
2.5. Solubility and Gel Fraction
2.6. Weight Loss
2.7. Mechanical Properties
2.8. The pH Levels
2.9. The Scanning Electron Microscopy and X-ray Spectroscopy
2.10. The Antibacterial Activity
3. Results
3.1. Water Vapor Transmission Rate (WVTR)
3.2. UV–Visible Spectroscopy
3.3. Starch-Based Films’ Swelling Index
3.4. Solubility and Gel Fraction
3.5. Weight Loss
3.6. Mechanical Strength
3.7. The pH Levels
3.8. SEM and X-ray Spectroscopy Measurements
3.9. Antibacterial-Property Evaluation
3.10. Biodegradability Analysis
4. Discussion
5. Conclusions
Supplementary Materials
Author Contributions
Funding
Institutional Review Board Statement
Informed Consent Statement
Data Availability Statement
Conflicts of Interest
References
- Russo, M.A.; O’Sullivan, C.; Rounsefell, B.; Halley, P.J.; Truss, R.; Clarke, W.P. The anaerobic degradability of thermoplastic starch: Polyvinyl alcohol blends: Potential biodegradable food packaging materials. Bioresour. Technol. 2009, 100, 1705–1710. [Google Scholar] [CrossRef] [PubMed]
- Geyer, R.; Jambeck, J.R.; Law, K.L. Production, use, and fate of all plastics ever made. Sci. Adv. 2017, 3, e1700782. [Google Scholar] [CrossRef] [PubMed] [Green Version]
- Hassan, A.; Niazi, M.B.K.; Hussain, A.; Farrukh, S.; Ahmad, T. Development of anti-bacterial PVA/starch based hydrogel membrane for wound dressing. J. Polym. Environ. 2018, 26, 235–243. [Google Scholar] [CrossRef]
- Das, A.; Uppaluri, R.; Das, C. Feasibility of poly-vinyl alcohol/starch/glycerol/citric acid composite films for wound dressing applications. Int. J. Biol. Macromol. 2019, 131, 998–1007. [Google Scholar] [CrossRef] [PubMed]
- Costa, N.N.; de Faria Lopes, L.; Ferreira, D.F.; de Prado, E.M.L.; Severi, J.A.; Resende, J.A.; de Paula Careta, F.; Ferreira, M.C.P.; Carreira, L.G.; de Souza, S.O.L. Polymeric films containing pomegranate peel extract based on PVA/starch/PAA blends for use as wound dressing: In vitro analysis and physicochemical evaluation. Mater. Sci. Eng. C 2020, 109, 110643. [Google Scholar] [CrossRef]
- Lian, R.; Cao, J.; Jiang, X.; Rogachev, A.V. Physicochemical, antibacterial properties and cytocompatibility of starch/chitosan films incorporated with zinc oxide nanoparticles. Mater. Today Commun. 2021, 27, 102265. [Google Scholar] [CrossRef]
- Ahmad, A.A.; Sarbon, N.M. A comparative study: Physical, mechanical and antibacterial properties of bio-composite gelatin films as influenced by chitosan and zinc oxide nanoparticles incorporation. Food Biosci. 2021, 43, 101250. [Google Scholar] [CrossRef]
- Khan, M.I.H.; Islam, J.M.; Kabir, W.; Rahman, A.; Mizan, M.; Rahman, M.F.; Amin, J.; Khan, M.A. Development of hydrocolloid Bi-layer dressing with bio-adhesive and non-adhesive properties. Mater. Sci. Eng. C 2016, 69, 609–615. [Google Scholar] [CrossRef]
- Sen, C.K. Human Wound and Its Burden: Updated 2020 Compendium of Estimates; Mary Ann Liebert, Inc.: Larchmont, NY, USA, 2021. [Google Scholar]
- Liu, H.; Adhikari, R.; Guo, Q.; Adhikari, B. Preparation and characterization of glycerol plasticized (high-amylose) starch–chitosan films. J. Food Eng. 2013, 116, 588–597. [Google Scholar] [CrossRef]
- Estevez-Areco, S.; Guz, L.; Famá, L.; Candal, R.; Goyanes, S. Bioactive starch nanocomposite films with antioxidant activity and enhanced mechanical properties obtained by extrusion followed by thermo-compression. Food Hydrocoll. 2019, 96, 518–528. [Google Scholar] [CrossRef]
- Anugrahwidya, R.; Armynah, B.; Tahir, D. Bioplastics Starch-Based with Additional Fiber and Nanoparticle: Characteristics and Biodegradation Performance: A Review. J. Polym. Environ. 2021, 29, 3459–3476. [Google Scholar] [CrossRef]
- Saini, I.; Sharma, A.; Dhiman, R.; Aggarwal, S.; Ram, S.; Sharma, P.K. Grafted SiC nanocrystals: For enhanced optical, electrical and mechanical properties of polyvinyl alcohol. J. Alloys Compd. 2017, 714, 172–180. [Google Scholar] [CrossRef]
- Aslam, M.; Kalyar, M.A.; Raza, Z.A. Polyvinyl alcohol: A review of research status and use of polyvinyl alcohol based nanocomposites. Polym. Eng. Sci. 2018, 58, 2119–2132. [Google Scholar] [CrossRef]
- Shi, R.; Bi, J.; Zhang, Z.; Zhu, A.; Chen, D.; Zhou, X.; Zhang, L.; Tian, W. The effect of citric acid on the structural properties and cytotoxicity of the polyvinyl alcohol/starch films when molding at high temperature. Carbohydr. Polym. 2008, 74, 763–770. [Google Scholar] [CrossRef]
- Wu, Z.; Wu, J.; Peng, T.; Li, Y.; Lin, D.; Xing, B.; Li, C.; Yang, Y.; Yang, L.; Zhang, L. Preparation and application of starch/polyvinyl alcohol/citric acid ternary blend antimicrobial functional food packaging films. Polymers 2017, 9, 102. [Google Scholar] [CrossRef]
- Amni, C.; Ismet, A.S.; Akbar, S. Mechanical properties of bioplastics janeng starch (Dioscorea hispida) film with glycerol and zinc oxide as reinforcement. Rasayan J. Chem. 2020, 13, 275–281. [Google Scholar] [CrossRef]
- Haider, A.; Haider, S.; Kang, I.-K.; Kumar, A.; Kummara, M.R.; Kamal, T.; Han, S.S. A novel use of cellulose based filter paper containing silver nanoparticles for its potential application as wound dressing agent. Int. J. Biol. Macromol. 2018, 108, 455–461. [Google Scholar] [CrossRef]
- Khorasani, M.T.; Joorabloo, A.; Moghaddam, A.; Shamsi, H.; MansooriMoghadam, Z. Incorporation of ZnO nanoparticles into heparinised polyvinyl alcohol/chitosan hydrogels for wound dressing application. Int. J. Biol. Macromol. 2018, 114, 1203–1215. [Google Scholar] [CrossRef]
- Delavari, M.M.; Stiharu, I. Biodegradable Starch-Based Polyvinyl Alcohol Films with Zinc-Oxide Particles for Wound Dressing Applications. In Proceedings of the International Conference on Reliable Systems Engineering, Bucharest, Romania, 9–10 September 2021; pp. 171–181. [Google Scholar]
- Espitia, P.J.P.; Soares, N.d.F.F.; dos Reis Coimbra, J.S.; de Andrade, N.J.; Cruz, R.S.; Medeiros, E.A.A. Zinc oxide nanoparticles: Synthesis, antimicrobial activity and food packaging applications. Food Bioprocess Technol. 2012, 5, 1447–1464. [Google Scholar] [CrossRef]
- Tankhiwale, R.; Bajpai, S. Preparation, characterization and antibacterial applications of ZnO-nanoparticles coated polyethylene films for food packaging. Colloids Surf. B Biointerfaces 2012, 90, 16–20. [Google Scholar] [CrossRef]
- Akhavan, A.; Khoylou, F.; Ataeivarjovi, E. Preparation and characterization of gamma irradiated Starch/PVA/ZnO nanocomposite films. Radiat. Phys. Chem. 2017, 138, 49–53. [Google Scholar] [CrossRef]
- Hu, M.; Li, C.; Li, X.; Zhou, M.; Sun, J.; Sheng, F.; Shi, S.; Lu, L. Zinc oxide/silver bimetallic nanoencapsulated in PVP/PCL nanofibres for improved antibacterial activity. Artif. Cells Nanomed. Biotechnol. 2018, 46, 1248–1257. [Google Scholar] [CrossRef] [PubMed] [Green Version]
- Tamimi, N.; Mohammadi Nafchi, A.; Hashemi-Moghaddam, H.; Baghaie, H. The effects of nano-zinc oxide morphology on functional and antibacterial properties of tapioca starch bionanocomposite. Food Sci. Nutr. 2021, 9, 4497–4508. [Google Scholar] [CrossRef]
- Rakhshaei, R.; Namazi, H. A potential bioactive wound dressing based on carboxymethyl cellulose/ZnO impregnated MCM-41 nanocomposite hydrogel. Mater. Sci. Eng. C 2017, 73, 456–464. [Google Scholar] [CrossRef] [PubMed]
- Amjadi, S.; Emaminia, S.; Nazari, M.; Davudian, S.H.; Roufegarinejad, L.; Hamishehkar, H. Application of reinforced ZnO nanoparticle-incorporated gelatin bionanocomposite film with chitosan nanofiber for packaging of chicken fillet and cheese as food models. Food Bioprocess Technol. 2019, 12, 1205–1219. [Google Scholar] [CrossRef]
- Espitia, P.; Otoni, C.; Soares, N. Zinc oxide nanoparticles for food packaging applications. In Antimicrobial Food Packaging; Elsevier: Amsterdam, The Netherlands, 2016; pp. 425–431. [Google Scholar]
- Lee, S.H.; Lee, H.R.; Kim, Y.-R.; Kim, M.-K. Toxic response of zinc oxide nanoparticles in human epidermal keratinocyte HaCaT cells. Toxicol. Environ. Health Sci. 2012, 4, 14–18. [Google Scholar] [CrossRef]
- Martin, C.; Low, W.L.; Amin, M.C.I.M.; Radecka, I.; Raj, P.; Kenward, K. Current trends in the development of wound dressings, biomaterials and devices. Pharm. Pat. Anal. 2013, 2, 341–359. [Google Scholar] [CrossRef]
- Kuo, S.-H.; Shen, C.-J.; Shen, C.-F.; Cheng, C.-M. Role of pH value in clinically relevant diagnosis. Diagnostics 2020, 10, 107. [Google Scholar] [CrossRef] [Green Version]
- Morgado, P.I.; Aguiar-Ricardo, A.; Correia, I.J. Asymmetric membranes as ideal wound dressings: An overview on production methods, structure, properties and performance relationship. J. Membr. Sci. 2015, 490, 139–151. [Google Scholar] [CrossRef]
- Goh, M.; Hwang, Y.; Tae, G. Epidermal growth factor loaded heparin-based hydrogel sheet for skin wound healing. Carbohydr. Polym. 2016, 147, 251–260. [Google Scholar] [CrossRef]
- Abdullah, A.H.D.; Putri, O.D.; Fikriyyah, A.K.; Nissa, R.C.; Hidayat, S.; Septiyanto, R.F.; Karina, M.; Satoto, R. Harnessing the excellent mechanical, barrier and antimicrobial properties of zinc oxide (ZnO) to improve the performance of starch-based bioplastic. Polym.-Plast. Technol. Mater. 2020, 59, 1259–1267. [Google Scholar] [CrossRef]
- Jayakumar, A.; Heera, K.; Sumi, T.; Joseph, M.; Mathew, S.; Praveen, G.; Nair, I.C.; Radhakrishnan, E. Starch-PVA composite films with zinc-oxide nanoparticles and phytochemicals as intelligent pH sensing wraps for food packaging application. Int. J. Biol. Macromol. 2019, 136, 395–403. [Google Scholar] [CrossRef] [PubMed]
- Pal, K.; Banthia, A.K.; Majumdar, D.K. Preparation and characterization of polyvinyl alcohol-gelatin hydrogel membranes for biomedical applications. Aaps Pharmscitech. 2007, 8, E142–E146. [Google Scholar] [CrossRef]
- Tunç, S.; Duman, O. Preparation and characterization of biodegradable methyl cellulose/montmorillonite nanocomposite films. Appl. Clay Sci. 2010, 48, 414–424. [Google Scholar] [CrossRef]
- Nafchi, A.M.; Nassiri, R.; Sheibani, S.; Ariffin, F.; Karim, A. Preparation and characterization of bionanocomposite films filled with nanorod-rich zinc oxide. Carbohydr. Polym. 2013, 96, 233–239. [Google Scholar] [CrossRef]
- Ngo, T.M.P.; Dang, T.M.Q.; Tran, T.X.; Rachtanapun, P. Effects of zinc oxide nanoparticles on the properties of pectin/alginate edible films. Int. J. Polym. Sci. 2018, 2018, 1–9. [Google Scholar] [CrossRef] [Green Version]
- Guo, S.A.; DiPietro, L.A. Factors affecting wound healing. J. Dent. Res. 2010, 89, 219–229. [Google Scholar] [CrossRef]
- Alavarse, A.C.; de Oliveira Silva, F.W.; Colque, J.T.; da Silva, V.M.; Prieto, T.; Venancio, E.C.; Bonvent, J.-J. Tetracycline hydrochloride-loaded electrospun nanofibers mats based on PVA and chitosan for wound dressing. Mater. Sci. Eng. C 2017, 77, 271–281. [Google Scholar] [CrossRef]
- Liu, Y.-J.; He, L.-L.; Mustapha, A.; Li, H.; Hu, Z.; Lin, M.-S. Antibacterial activities of zinc oxide nanoparticles against Escherichia coli O157: H7. J. Appl. Microbiol. 2009, 107, 1193–1201. [Google Scholar] [CrossRef]
- Liu, Y.; Geever, L.M.; Kennedy, J.E.; Higginbotham, C.L.; Cahill, P.A.; McGuinness, G.B. Thermal behavior and mechanical properties of physically crosslinked PVA/Gelatin hydrogels. J. Mech. Behav. Biomed. Mater. 2010, 3, 203–209. [Google Scholar] [CrossRef]
- Hoseinnejad, M.; Jafari, S.M.; Katouzian, I. Inorganic and metal nanoparticles and their antimicrobial activity in food packaging applications. Crit. Rev. Microbiol. 2018, 44, 161–181. [Google Scholar] [CrossRef] [PubMed]
- Seligra, P.G.; Jaramillo, C.M.; Famá, L.; Goyanes, S. Biodegradable and non-retrogradable eco-films based on starch–glycerol with citric acid as crosslinking agent. Carbohydr. Polym. 2016, 138, 66–74. [Google Scholar] [CrossRef] [PubMed] [Green Version]
- Ounkaew, A.; Kasemsiri, P.; Kamwilaisak, K.; Saengprachatanarug, K.; Mongkolthanaruk, W.; Souvanh, M.; Pongsa, U.; Chindaprasirt, P. Polyvinyl alcohol (PVA)/starch bioactive packaging film enriched with antioxidants from spent coffee ground and citric acid. J. Polym. Environ. 2018, 26, 3762–3772. [Google Scholar] [CrossRef]
- Yoon, S.D.; Chough, S.H.; Park, H.R. Properties of starch-based blend films using citric acid as additive. II. J. Appl. Polym. Sci. 2006, 100, 2554–2560. [Google Scholar] [CrossRef]
- Chopra, P.; Nayak, D.; Nanda, A.; Ashe, S.; Rauta, P.R.; Nayak, B. Fabrication of poly (vinyl alcohol)-Carrageenan scaffolds for cryopreservation: Effect of composition on cell viability. Carbohydr. Polym. 2016, 147, 509–516. [Google Scholar] [CrossRef]
- Chuang, C.Y.; Shahin, K.; Lord, M.S.; Melrose, J.; Doran, P.M.; Whitelock, J.M. The cartilage matrix molecule components produced by human foetal cartilage rudiment cells within scaffolds and the role of exogenous growth factors. Biomaterials 2012, 33, 4078–4088. [Google Scholar] [CrossRef]
- Chen, H.; Xing, X.; Tan, H.; Jia, Y.; Zhou, T.; Chen, Y.; Ling, Z.; Hu, X. Covalently antibacterial alginate-chitosan hydrogel dressing integrated gelatin microspheres containing tetracycline hydrochloride for wound healing. Mater. Sci. Eng. C 2017, 70, 287–295. [Google Scholar] [CrossRef]
- Rouhi, J.; Mahmud, S.; Naderi, N.; Ooi, C.R.; Mahmood, M.R. Physical properties of fish gelatin-based bio-nanocomposite films incorporated with ZnO nanorods. Nanoscale Res. Lett. 2013, 8, 364. [Google Scholar] [CrossRef] [Green Version]
- Fahmy, A.; Kamoun, E.A.; El-Eisawy, R.; El-Fakharany, E.M.; Taha, T.H.; El-Damhougy, B.K.; Abdelhai, F. Poly (vinyl alcohol)-hyaluronic acid membranes for wound dressing applications: Synthesis and in vitro bio-evaluations. J. Braz. Chem. Soc. 2015, 26, 1466–1474. [Google Scholar] [CrossRef]

| Starch (g) | PVA (g) | Citric Acid (g) | Glycerol (g) | nZnO (g) | |
|---|---|---|---|---|---|
| SPCG | 2.5 | 2.5 | 0.5 | 2 | - |
| S1 | 2.5 | 2.5 | 0.5 | 2 | 0.2 |
| S2 | 2.5 | 2.5 | 0.5 | 2 | 0.25 |
| S3 | 2.5 | 2.5 | 0.5 | 2 | 0.3 |
| S4 | 2.5 | 2.5 | 0.5 | 2 | 0.35 |
Publisher’s Note: MDPI stays neutral with regard to jurisdictional claims in published maps and institutional affiliations. |
© 2022 by the authors. Licensee MDPI, Basel, Switzerland. This article is an open access article distributed under the terms and conditions of the Creative Commons Attribution (CC BY) license (https://creativecommons.org/licenses/by/4.0/).
Share and Cite
Delavari, M.M.; Stiharu, I. Preparing and Characterizing Novel Biodegradable Starch/PVA-Based Films with Nano-Sized Zinc-Oxide Particles for Wound-Dressing Applications. Appl. Sci. 2022, 12, 4001. https://doi.org/10.3390/app12084001
Delavari MM, Stiharu I. Preparing and Characterizing Novel Biodegradable Starch/PVA-Based Films with Nano-Sized Zinc-Oxide Particles for Wound-Dressing Applications. Applied Sciences. 2022; 12(8):4001. https://doi.org/10.3390/app12084001
Chicago/Turabian StyleDelavari, Mohammad Mohsen, and Ion Stiharu. 2022. "Preparing and Characterizing Novel Biodegradable Starch/PVA-Based Films with Nano-Sized Zinc-Oxide Particles for Wound-Dressing Applications" Applied Sciences 12, no. 8: 4001. https://doi.org/10.3390/app12084001
APA StyleDelavari, M. M., & Stiharu, I. (2022). Preparing and Characterizing Novel Biodegradable Starch/PVA-Based Films with Nano-Sized Zinc-Oxide Particles for Wound-Dressing Applications. Applied Sciences, 12(8), 4001. https://doi.org/10.3390/app12084001

